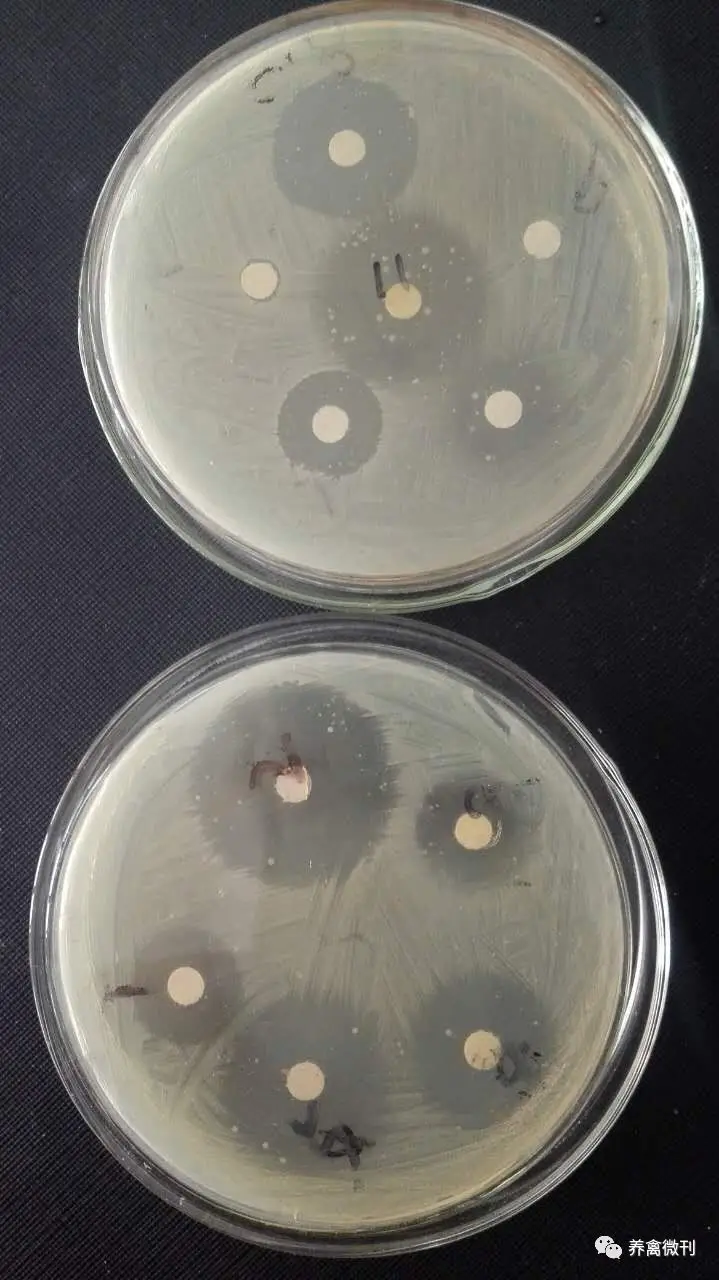
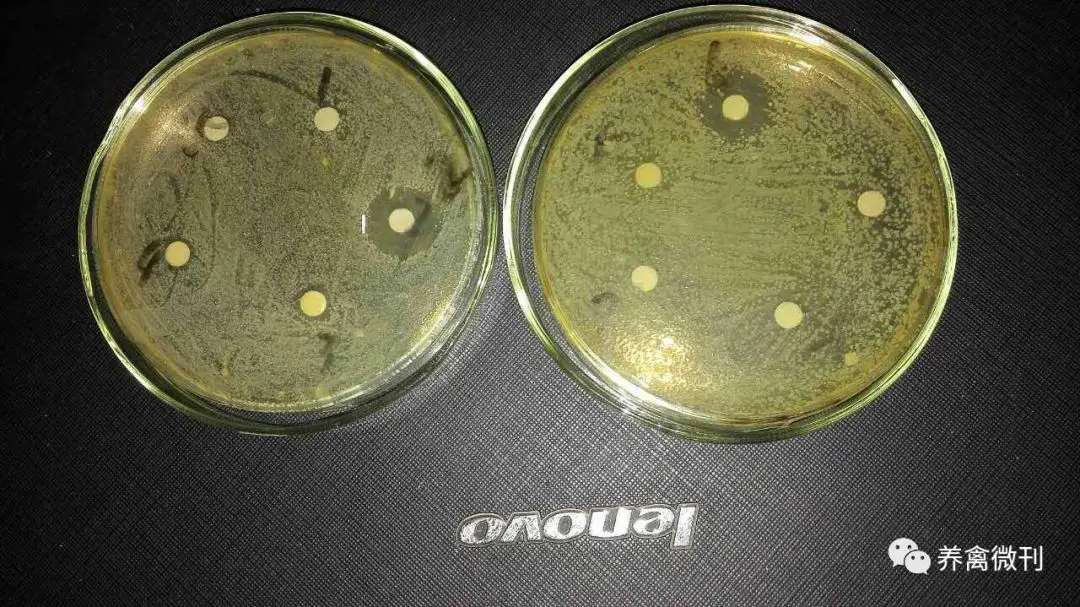

养禽业的移动互联网综合服务平台,让好产品找到“好伯乐”,让好用户找到“千里马”,加微信13523003677,与我们一同前行,让养殖更轻松!



[主要成分]
葡萄糖氧化酶、氟洛培南、磷霉素钠、药酶抑制剂等
[产品特点]
1、安全:本品药理作用主要是通过抑制细菌细胞壁的生成,以达到杀菌目的。因动物细胞
没有细胞壁,所有没有任何毒副作用。雏鸡作为开口药,能减少母源传播性疾病,提高雏鸡成活率。
2、高效:采用纳米包被专利制备工艺,口服吸收好,生物利用度高,几乎达到100%,有效血药浓度维持24小时以上。
3、低耐:独特的组方配合药酶抑制剂,使本品对大肠杆菌、沙门氏菌等致病菌没有耐药性。通过各地大量的药敏试验和临床使用验证,本品在同类抗菌药物中疗效始终领先。
药敏试验

2号为杆特威
2号为杆特威

1号为杆特威
[主 治]
1、禽(鸡、鸭、鹅、鹌鹑、鸽子)大肠杆菌病、沙门氏菌病、巴氏杆菌病、葡萄球菌等细菌性疾病引起的家禽心包炎、肝周炎、气囊炎、输卵管炎、卵黄性腹膜炎、眼炎、脐炎、滑膜炎、白痢、肠炎等。
2、鸭传染性浆膜炎。
3、猪副嗜血杆菌、传染性胸膜肺炎、猪链球菌、伤寒、副伤寒、葡萄球菌、猪丹毒、猪肺疫、仔猪黄白痢、大肠杆菌病、无乳综合征等细菌性病。
[用法用量]
1、禽(鸡、鸭、鹅、鹌鹑、鸽子):本品每瓶120g兑水300kg,建议将全天用药量集中一次使用,连用3-5天。重症酌情加量。雏鸡开口,每瓶120g用于3000只肉鸡或5000只蛋鸡集中饮水4个小时,一天一次,连用4天,可有效的预防沙门氏菌和大肠杆菌,保证育雏期的成活率。
2、猪:本品每瓶120g拌料150kg,连用5—7天,重症酌情加量。
[包 装]
120g/瓶×80瓶/箱
[指导用药]
1、建议用药时间安排在上午8:00-10:00集中投药,效果更好。
2、如有气囊炎混感,需配合气囊速治使用,连用3-4天。


销售热线:邵 总:18637128369
技术热线:许经理:13523003677


